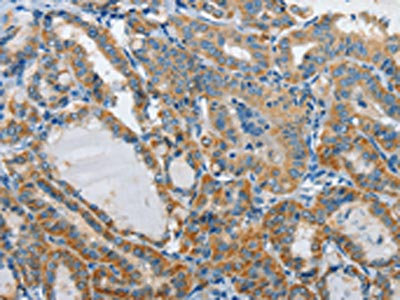

GZMB Antibody
-
中文名稱:GZMB兔多克隆抗體
-
貨號:CSB-PA986806
-
規格:¥1100
-
圖片:
-
其他:
產品詳情
-
Uniprot No.:
-
基因名:
-
別名:C11 antibody; Cathepsin G like 1 antibody; Cathepsin G-like 1 antibody; CCPI antibody; CGL 1 antibody; CGL1 antibody; CSP B antibody; CSPB antibody; CTLA 1 antibody; CTLA-1 antibody; CTLA1 antibody; CTSGL1 antibody; Cytotoxic serine protease B antibody; Cytotoxic T lymphocyte associated serine esterase 1 antibody; Cytotoxic T lymphocyte proteinase 2 antibody; Cytotoxic T-lymphocyte proteinase 2 antibody; Fragmentin 2 antibody; Fragmentin-2 antibody; GRAB_HUMAN antibody; Granzyme 2 antibody; Granzyme B (granzyme 2; cytotoxic T lymphocyte associated serine esterase 1) antibody; Granzyme B antibody; Granzyme-2 antibody; GranzymeB antibody; GRB antibody; Gzmb antibody; Hlp antibody; Human lymphocyte protein antibody; Lymphocyte protease antibody; Protease; serine; B antibody; SECT antibody; T cell serine protease 1 3E antibody; T cell serine protease 1-3E antibody; T-cell serine protease 1-3E antibody
-
宿主:Rabbit
-
反應種屬:Human
-
免疫原:Fusion protein of Human GZMB
-
免疫原種屬:Homo sapiens (Human)
-
標記方式:Non-conjugated
-
抗體亞型:IgG
-
純化方式:Antigen affinity purification
-
濃度:It differs from different batches. Please contact us to confirm it.
-
保存緩沖液:-20°C, pH7.4 PBS, 0.05% NaN3, 40% Glycerol
-
產品提供形式:Liquid
-
應用范圍:ELISA,IHC
-
推薦稀釋比:
Application Recommended Dilution ELISA 1:2000-1:5000 IHC 1:25-1:100 -
Protocols:
-
儲存條件:Upon receipt, store at -20°C or -80°C. Avoid repeated freeze.
-
貨期:Basically, we can dispatch the products out in 1-3 working days after receiving your orders. Delivery time maybe differs from different purchasing way or location, please kindly consult your local distributors for specific delivery time.
-
用途:For Research Use Only. Not for use in diagnostic or therapeutic procedures.
相關產品
靶點詳情
-
功能:Abundant protease in the cytosolic granules of cytotoxic T-cells and NK-cells which activates caspase-independent pyroptosis when delivered into the target cell through the immunological synapse. It cleaves after Asp. Once delivered into the target cell, acts by catalyzing cleavage of gasdermin-E (GSDME), releasing the pore-forming moiety of GSDME, thereby triggering pyroptosis and target cell death. Seems to be linked to an activation cascade of caspases (aspartate-specific cysteine proteases) responsible for apoptosis execution. Cleaves caspase-3, -7, -9 and 10 to give rise to active enzymes mediating apoptosis.
-
基因功能參考文獻:
- our exploratory study suggests that EOMES, BCL6 and GZMB gene expression are aberrant within the PB T cell transcriptome of HT patients. The association of this transcription signature with the heterogeneity of HT and disease control is suggested. PMID: 29319368
- Serum interleukin 1 receptor antagonist (IL1RA) and granzyme B (GZMB) levels were markedly increased in Crohn's disease (CD) patients, suggesting that these markers can serve as biomarkers to identify gut inflammation. PMID: 28972805
- Authors found that R(48)-GzmB is a stable protein that accumulates to similar levels in activated NK cells as Q(48)-GzmB. rs8192917 polymorphism may influence antitumor activity and the effect of antitumor cellular immunotherapy. PMID: 28653095
- GzmA and gzmB were predominantly expressed by natural killer cells, and during abdominal sepsis, the percentage of these cells expressing gzms in peritoneal lavage fluid decreased, while the amount of expression in the gzm(+) cells increased PMID: 28694562
- Study provides evidence that Il10 expression is limited to migratory CD25++ regulatory T cells only. PMID: 27756896
- Long-term lung function decline in asthma is associated with elevation of bronchial CD8 and CD4 at baseline, and CD8, CD3 and granzyme B at follow-up PMID: 27230446
- Granzyme B breaches the inner membrane through Tim22, the metabolite carrier translocase pore, in a mitochondrial heat-shock protein 70-dependent manner. PMID: 28338658
- Differential proteomics were used to identify granzyme B substrates in three unrelated bacteria: Escherichia coli, Listeria monocytogenes, and Mycobacteria tuberculosis. Granzyme B cleaves a highly conserved set of proteins in all three bacteria, which function in vital biosynthetic and metabolic pathways that are critical for bacterial survival under diverse environmental conditions. PMID: 29107333
- Proteolysis by granzyme B enhances presentation of autoantigenic PAD4 epitopes in rheumatoid arthritis. PMID: 27700100
- our results suggest granzyme B PET imaging can serve as a quantitatively useful predictive biomarker for efficacious responses to cancer immunotherapy. PMID: 28461564
- Plasma GzmB levels may reflect the degree of pruritus and dermatitis in patients with atopic dermatitis PMID: 27686401
- These results suggest the critical importance of miR-378 in the regulation of GrzB expression and a protective role for GrzB in controlling dengue virus replication in vivo. PMID: 26166761
- Analysis of infiltrating granzyme B-expressing T cells at the invasive borders of the colon tumors revealed a significant difference in expression granzyme by race underlining decreased antitumor cytotoxic immunity in African Americans. PMID: 27310868
- Increased TIM3+CD8+T cells with lower perforin and granzyme B expression and higher CD95 expression in MDS patients were observed. PMID: 27846431
- granzyme-B levels were found to be significantly associated with increased insulin resistance in adolescent polycystic ovary syndrome patients. Additionally, elevated levels of serum granzyme-B were predictive for increased cardiovascular risk in PCOS patients PMID: 26802256
- results suggest that enhanced IL-21R expression of CD19(+)CD5(+) B cells and production of IL-21 by iNKT cells may play an important role in the pathogenesis of pSS by regulating CD19(+)CD5(+) B cell functions and increasing GrB production, presumably leading to a counter-regulatory effect in the disease. PMID: 26884645
- Findings show that GrB was produced in 57.1% colorectal cancer cell (CRC) lines and 100% CRC-derived Cancer Stem Cells and present a novel role for GrB as up-modulator of epitelial-to-mesenchimal transition in CRC cells. PMID: 26830472
- FASL, granzyme B, and cytochrome c blood expression reflects breast cancer progression and response to therapy. (Review) PMID: 27117663
- Data show that NK cell lines could secreted rapidly inactive Mr 35 000 granzyme B (GZB)outside secretory lysosomes (SLs). PMID: 26927382
- Data suggest that reactive oxygen species (ROS) generated within cytotoxic lymphocytes by receptor stimulation are required for lysosomal permeabilization and release of GzmB (granzyme B) into the cytosol and for inactivation of serpin B9. PMID: 26670609
- these results suggest a perforin-independent, extracellular role for GzmB in the pathogenesis of cardiac fibrosis PMID: 26610869
- Among SLAMF4+ cells, the T cell fraction positive for perforin and granzyme B was higher in those obtained from healthy donors, while the percentage of T cells that were single-positive for granzyme B was higher in cells obtained from patients with SLE. PMID: 26314831
- Costimulation blockade by abatacept can decrease the serum levels of GZMB in rheumatoid arthritis patients responding to the treatment. PMID: 26633185
- elevated in the inflammatory lesions of placentas with villitis of unknown etiology PMID: 25725937
- Combined evaluation of granzyme B and perforin may have a role in noninvasive diagnosis of acute rejection after kidney transplantation. PMID: 25643139
- this study emphasizes that the coordinated action of hGzmB-activated p53 and GzmB-cleaved Bid is important for GzmB-induced cell death and for cytotoxic lymphocyte/Natural Killer Cell-mediated killing of target cells. PMID: 25404359
- identified among the key genes in circulating monocytes that were altered by exercise PMID: 26207425
- GB-induced ROS significantly promote apoptosis. PMID: 25361078
- Active secretion of CXCL10 and CCL5 from colorectal cancer microenvironments associates with granzymeB+ CD8+ T-cell infiltration. PMID: 25671296
- Synthetic consensus HIV-1 DNA induces potent cellular immune responses and synthesis of granzyme B, perforin in HIV infected individuals. PMID: 25531694
- GzmB plays no role in the pathogenesis of keloids and hypertrophic scars. PMID: 26410968
- PFN appears to form arc structures on target membranes that serve as minimally disrupting conduits for GzmB translocation. PMID: 25146929
- These results suggest that GZMB Q55R, P94A, and Y247H polymorphisms are not significantly associated with colon cancer incidence, or metastasis to lymph node and distant organ. PMID: 25313744
- CD4+ T cell-derived IL-21 and deprivation of CD40 signaling favor the in vivo development of granzyme B-expressing regulatory B cells in HIV patients. PMID: 25780036
- Data indicate that treatment with toll-like receptor 8 (TLR8) agonists elicited granzyme B production. PMID: 25667415
- The results of study found implicate possible effect of this genetic polymorphism in susceptibility to SSPE which needs to be confirmed in bigger populations. PMID: 24875585
- Activated CD4 and CD8 T cells secrete similar amounts of GrzB. PMID: 25245659
- The suppression-abrogating cytokine IL-6 augments GzmB expression by human CD4 T cells, and it inhibits Treg suppression via a nonapoptotic GzmB-mediated mechanism. PMID: 25637022
- Polarized granzyme release is required for antigen-driven transendothelial migration of human effector memory CD4 T cells. PMID: 25367116
- CASP is specifically cleaved by granzymeB. PMID: 25159843
- Serum concentrations of granzyme B in patients with ovarian cancer were substantially increased in comparison to concentrations in patients with ovarian cystadenomas or ovarian teratomas. PMID: 24673566
- The GrB-Sb9 nexus may therefore represent an additional mechanism of limiting lymphocyte lifespan and populations. PMID: 24488096
- our data indicate that the co-expression of perforin and granzyme B genes exhibits anticancer potential PMID: 24696715
- Cancer cells released soluble factors that inhibited granzyme B, perforin and IFN-gamma production. PMID: 24894428
- multiple linear regression analysis revealed that both type 2 diabetes mellitus and central obesity were predicting factors for GzmB, findings reveal a possible role of GzmB in type 2 diabetes mellitus. PMID: 24195710
- cleaves proIL-18 into active form and promotes apoptosis in the inflammed skin PMID: 23820889
- These results suggest that GrzB from CCR5+ memory CD4 T cells may have a role in cellular and tissue pathologies during HIV infection. PMID: 24999042
- These data indicate that IBD-related inflammation is marked by mucosal accumulation of cytotoxic, GrB-expressing CD19(+) and IgA(+) cells, suggesting a role for these cells in IBD-associated epithelial damage. PMID: 24835396
- Report increased granzyme B expression in discoid lupus erythematosus. PMID: 23980805
- Unlike IL-18 and FKN, plasma GZB may have a role in severity of acute coronary syndrome PMID: 24307760
顯示更多
收起更多
-
亞細胞定位:Secreted. Cytolytic granule.
-
蛋白家族:Peptidase S1 family, Granzyme subfamily
-
數據庫鏈接:
Most popular with customers
-
-
YWHAB Recombinant Monoclonal Antibody
Applications: ELISA, WB, IHC, IF, FC
Species Reactivity: Human, Mouse, Rat
-
Phospho-YAP1 (S127) Recombinant Monoclonal Antibody
Applications: ELISA, WB, IHC
Species Reactivity: Human
-
-
-
-
-